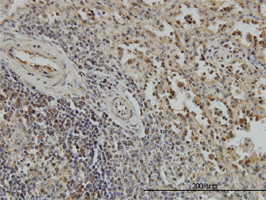

Filters
Clonality
Type
Reactivity
Gene Name
Isotype
Host
Application
Clone
576 results for " expressed in human cell line 293" - showing 550-576
HCLS1, Monoclonal Antibody (Cat# AAA25416)
RSK3, Monoclonal Antibody (Cat# AAA24939)
HCLS1, Monoclonal Antibody (Cat# AAA25711)
RSK3, Monoclonal Antibody (Cat# AAA25235)
MAPK8, Monoclonal Antibody (Cat# AAA24265)
MAPK8, Monoclonal Antibody (Cat# AAA24561)
RSK3, Monoclonal Antibody (Cat# AAA24347)
HCLS1, Monoclonal Antibody (Cat# AAA25122)
MAPK8, Monoclonal Antibody (Cat# AAA25153)
RSK3, Monoclonal Antibody (Cat# AAA24643)
b2-Microglobulin, Monoclonal Antibody (Cat# AAA14785)
Purified by Protein A affinity chromatography.
HCLS1, Monoclonal Antibody (Cat# AAA24530)
RSK3, Monoclonal Antibody (Cat# AAA25825)
RSK3, Monoclonal Antibody (Cat# AAA24063)
Purified by Protein A affinity chromatography.